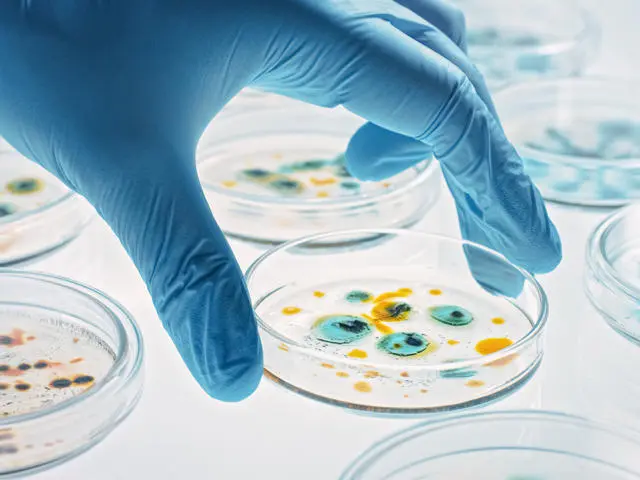

Our research and enterprise ecosystem
At Heriot-Watt University, our mission transcends the boundaries between research and enterprise. We've created an environment where academia, industry and partners collaborate to shape a future that's sustainable, inclusive and forward-thinking.
We introduce you to GRID - Global Research Innovation Discovery – our ecosystem that unites global challenges, impactful Research, enterprising Innovation and universal Discovery. This framework not only positions us at the forefront of tackling the world's complex problems but ensures we're leading with meaningful solutions.
Our heritage of over 200 years of research and industry engagement combined with our global footprint, offers both scale and agility. This is embodied in the GRID ecosystem, which enables us to shape global change effectively, in partnership.
86.8% of our research is ranked world-leading and internationally excellent.Research Excellence Framework 2021

Proofing the Future
Shaping a more sustainable future for brewing and distilling

Celebrating International Year of Quantum Science and Technology
Advancing quantum and photonics research for a transformative future

Postgraduate study opportunities
Shaping the future through education

Postgraduate research opportunities
Driving discovery and advancing knowledge

Listen to the 'On the GRID' podcast
From the bottom of the seabed to the far-reaches of space, each episode brings you closer to the ideas shaping tomorrow.
Our global research institutes
Heriot-Watt is home to four global research institutes, powerful convening platforms designed to foster targeted, multi-party research collaborations across diverse disciplines. Each Institute brings together leading experts, partners, and stakeholders from academia, industry, and government, creating dynamic ecosystems focused on solving pressing global challenges and advancing our ambitious global missions.

iNetZ+ Net Zero and Beyond
Pioneering groundbreaking solutions that will redefine environmental stewardship and propel us toward a carbon-neutral future.

The National Robotarium
A world-leading centre for Robotics and Artificial Intelligence, creating innovative solutions to global challenges.

The Lyell Centre
An inspired fusion of earth and marine science, the Lyell Centre's work spans both fundamental and applied research, using innovative technology to address global challenges
Health and Care Technologies
Turning cutting-edge research into impactful and practical solutions to make a positive impact on peoples’ lives, the NHS and health and care globally.
Get in touch
At Heriot-Watt University, we bring people, ideas, and resources together through multi-disciplinary research and transformative partnerships, creating powerful convening platforms to tackle global challenges. Our global research institutes serve as engines of impactful collaboration, while emerging innovation clusters—spanning quantum, photonics, and other frontier fields—ensure we drive sustainable, inclusive growth for generations to come.
Professor Richard A. Williams, Principal and Vice-Chancellor
Why Heriot-Watt?
Since 1821 we have been at the forefront of new ideas and solutions, creating radical innovations that make a difference in the real world. Heriot-Watt has an established reputation as a dynamic facilitator of successful strategic alliances. The University aims to solve problems of real significance to society by excelling in research and enterprise.